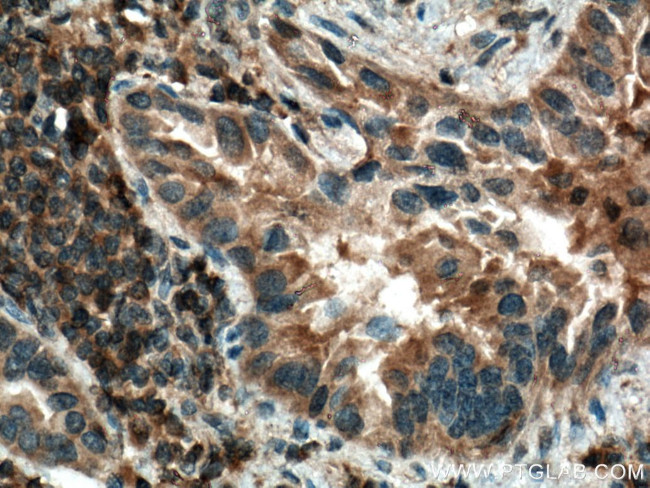
IRAK4 Antibody in Immunohistochemistry (Paraffin) (IHC (P))

Search
Proteintech
IRAK4 Polyclonal Antibody
{{$productOrderCtrl.translations['antibody.pdp.commerceCard.promotion.promotions']}}
{{$productOrderCtrl.translations['antibody.pdp.commerceCard.promotion.viewpromo']}}
{{$productOrderCtrl.translations['antibody.pdp.commerceCard.promotion.promocode']}}: {{promo.promoCode}} {{promo.promoTitle}} {{promo.promoDescription}}. {{$productOrderCtrl.translations['antibody.pdp.commerceCard.promotion.learnmore']}}
产品信息
18221-1-AP
种属反应
已发表种属
宿主/亚型
分类
类型
抗原
偶联物
形式
浓度
规格
纯化类型
保存液
内含物
保存条件
运输条件
产品详细信息
Immunogen sequence: MNKPITPST YVRCLNVGLI RKLSDFIDPQ EGWKKLAVAI KKPSGDDRYN QFHIRRFEAL LQTGKSPTSE LLFDWGTTNC TVGDLVDLLI QNEFFAPASL LLPDAVPKTA NTLPSKEAIT VQQKQMPFCD KDRTLMTPVQ NLEQSYMPPD SSSPENKSLE VSDTRFHSFS FYELKNVTNN FDERPISVGG NKMGEGGFGV V (1-200 aa encoded by BC013316)
靶标信息
IL-1 receptor associated kinases (IRAKs) are serine/threonine kinases involved in signaling via Toll/IL-1 pathways. Overexpression of IRAK-4 activates NF-kappa-B and MAPK pathways. IRAK-4 interacts with and phosphorylates IRAK-1. IRAK-4-deficient animals are completely resistant to the challenge with LPS. Animals and humans lacking IRAK-4 are impaired in their responses to viral and bacterial challenges. Members in IRAK/Pelle family play a central role in IL-1R/TLR mediated inflammatory responses and in innate immunity.
仅用于科研。不用于诊断过程。未经明确授权不得转售。
生物信息学
蛋白别名: interleukin-1; Interleukin-1 receptor-associated kinase 4; IRAK-4; IRAK-4 mutated form 1; IRAK-4 mutated form 2; IRAK4; protein kinase; IRAK4S; protein kinase; protein kinase; Renal carcinoma antigen NY-REN-64; unnamed protein product
基因别名: IMD67; IPD1; IRAK-4; IRAK4; NY-REN-64; REN64
UniProt ID: (Human) Q9NWZ3
Entrez Gene ID: (Human) 51135